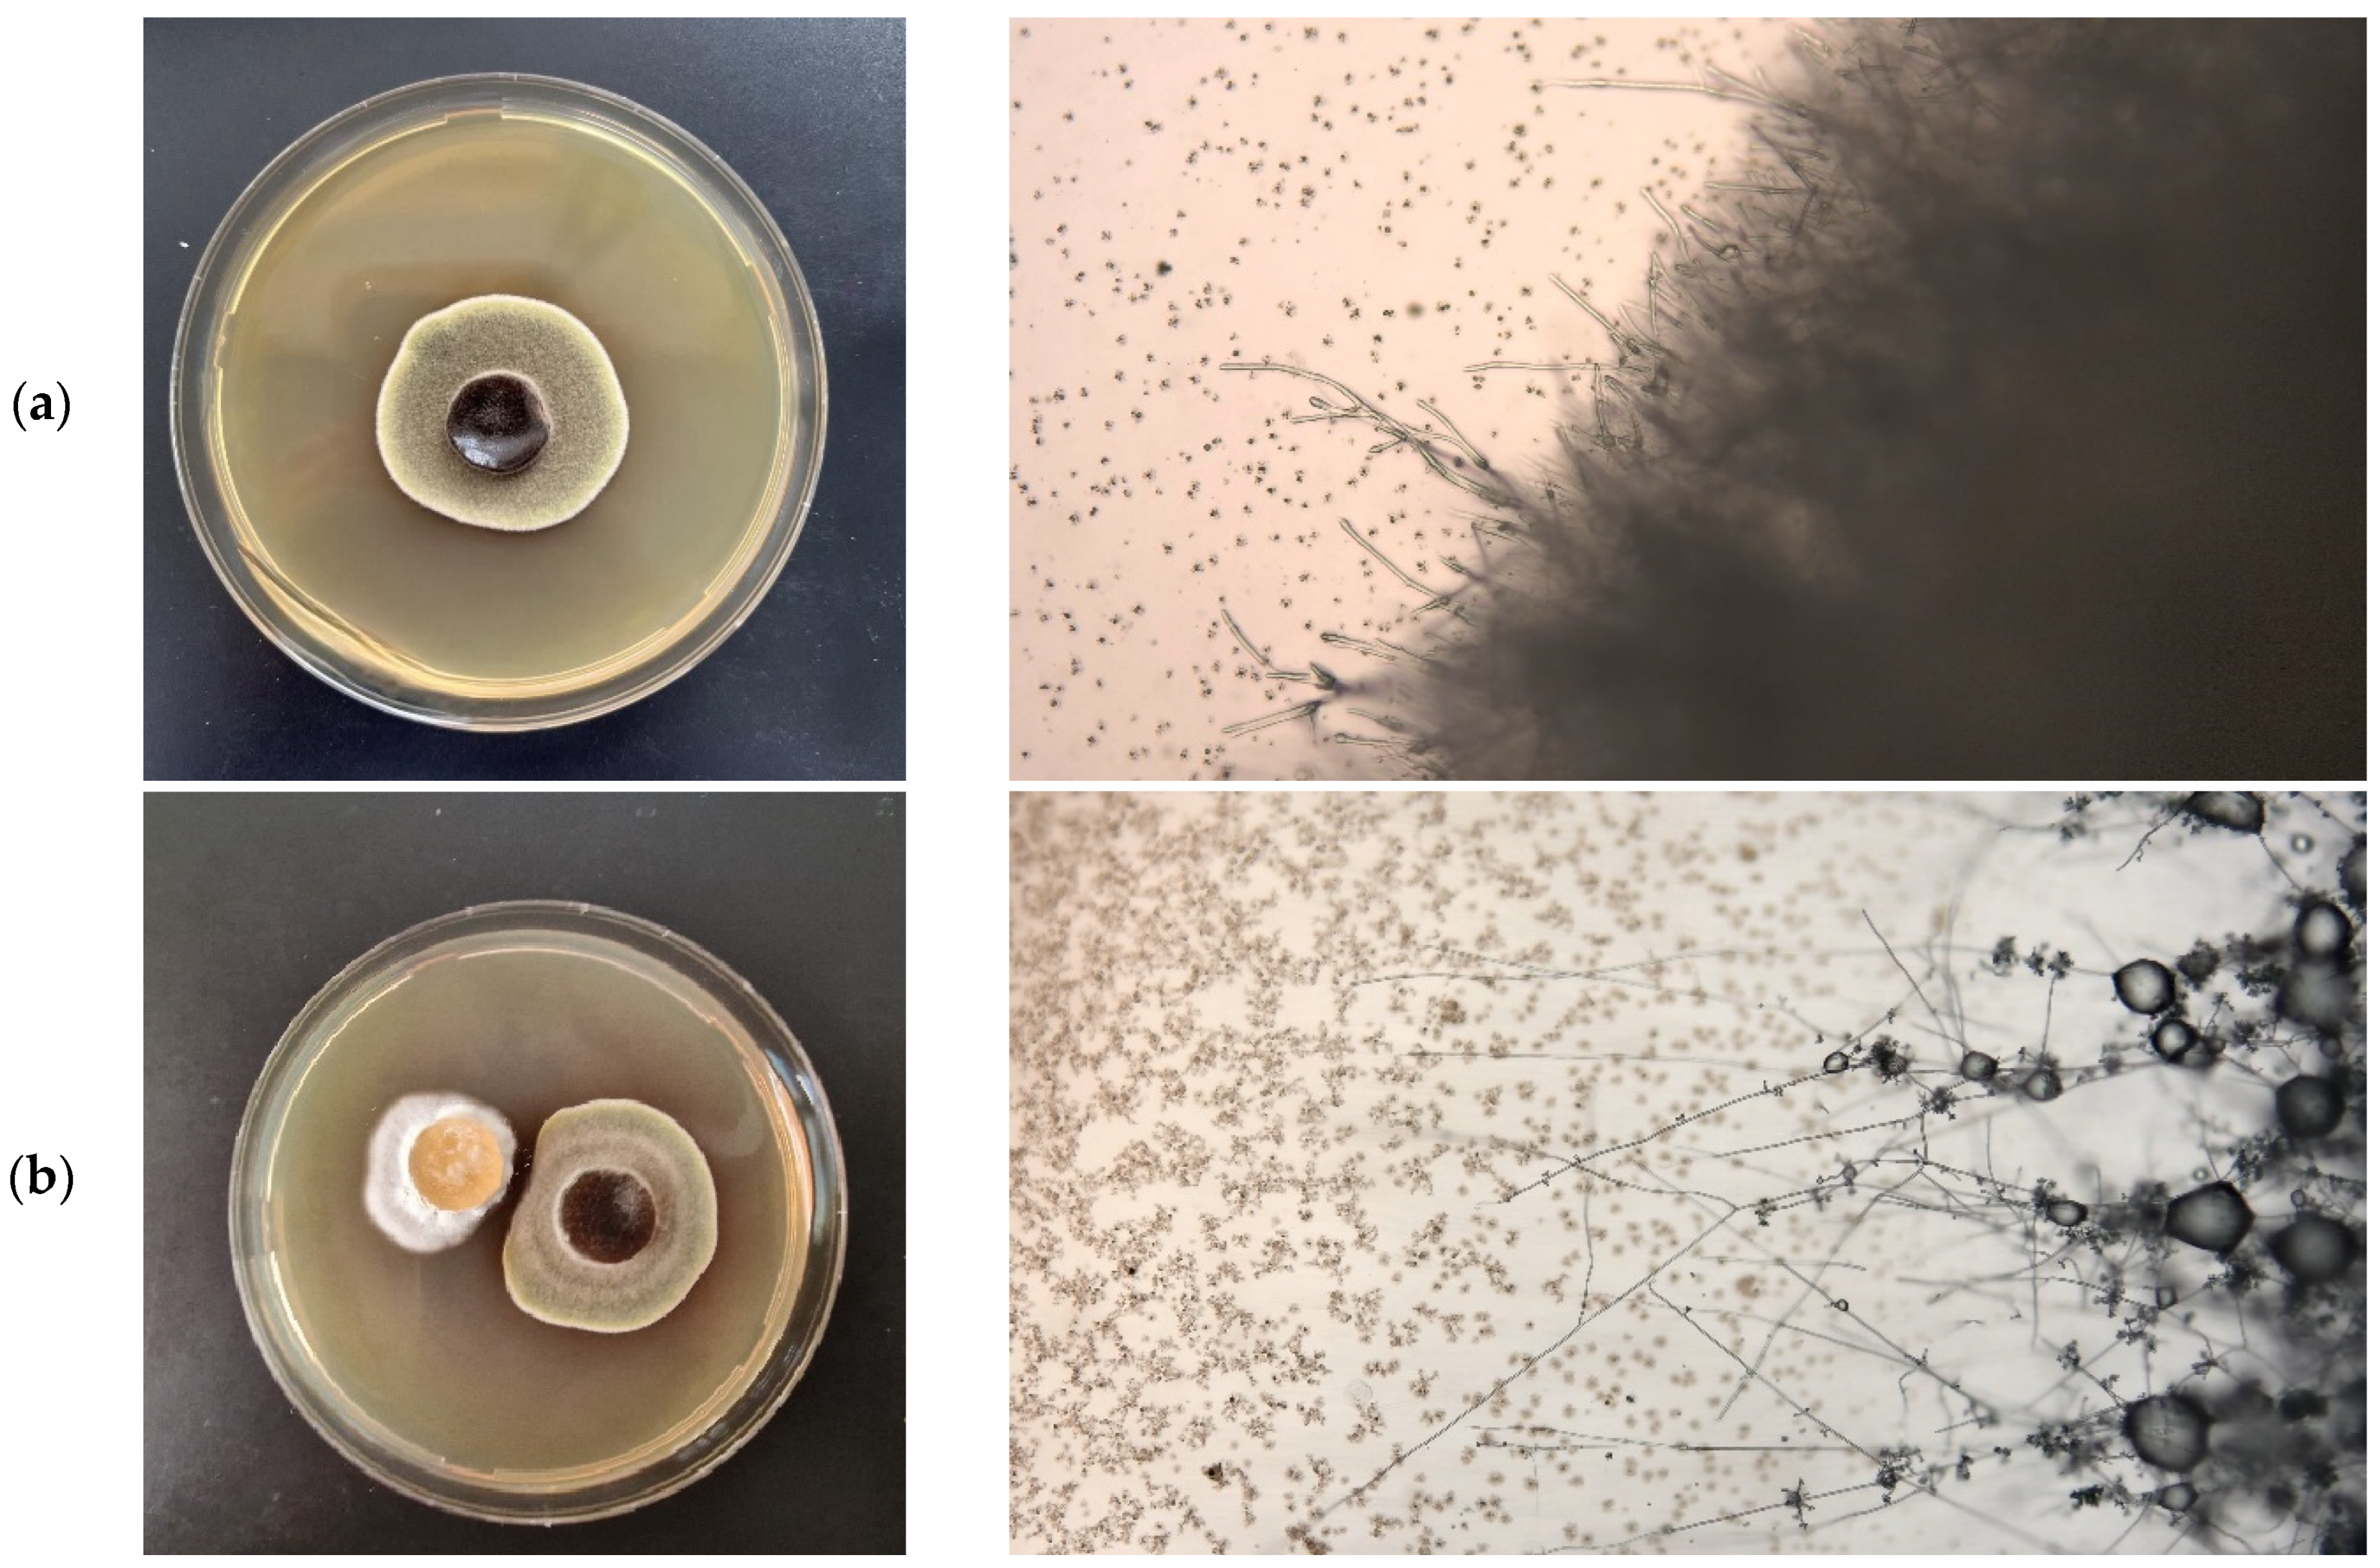
Sustainability 17 00450 g001a
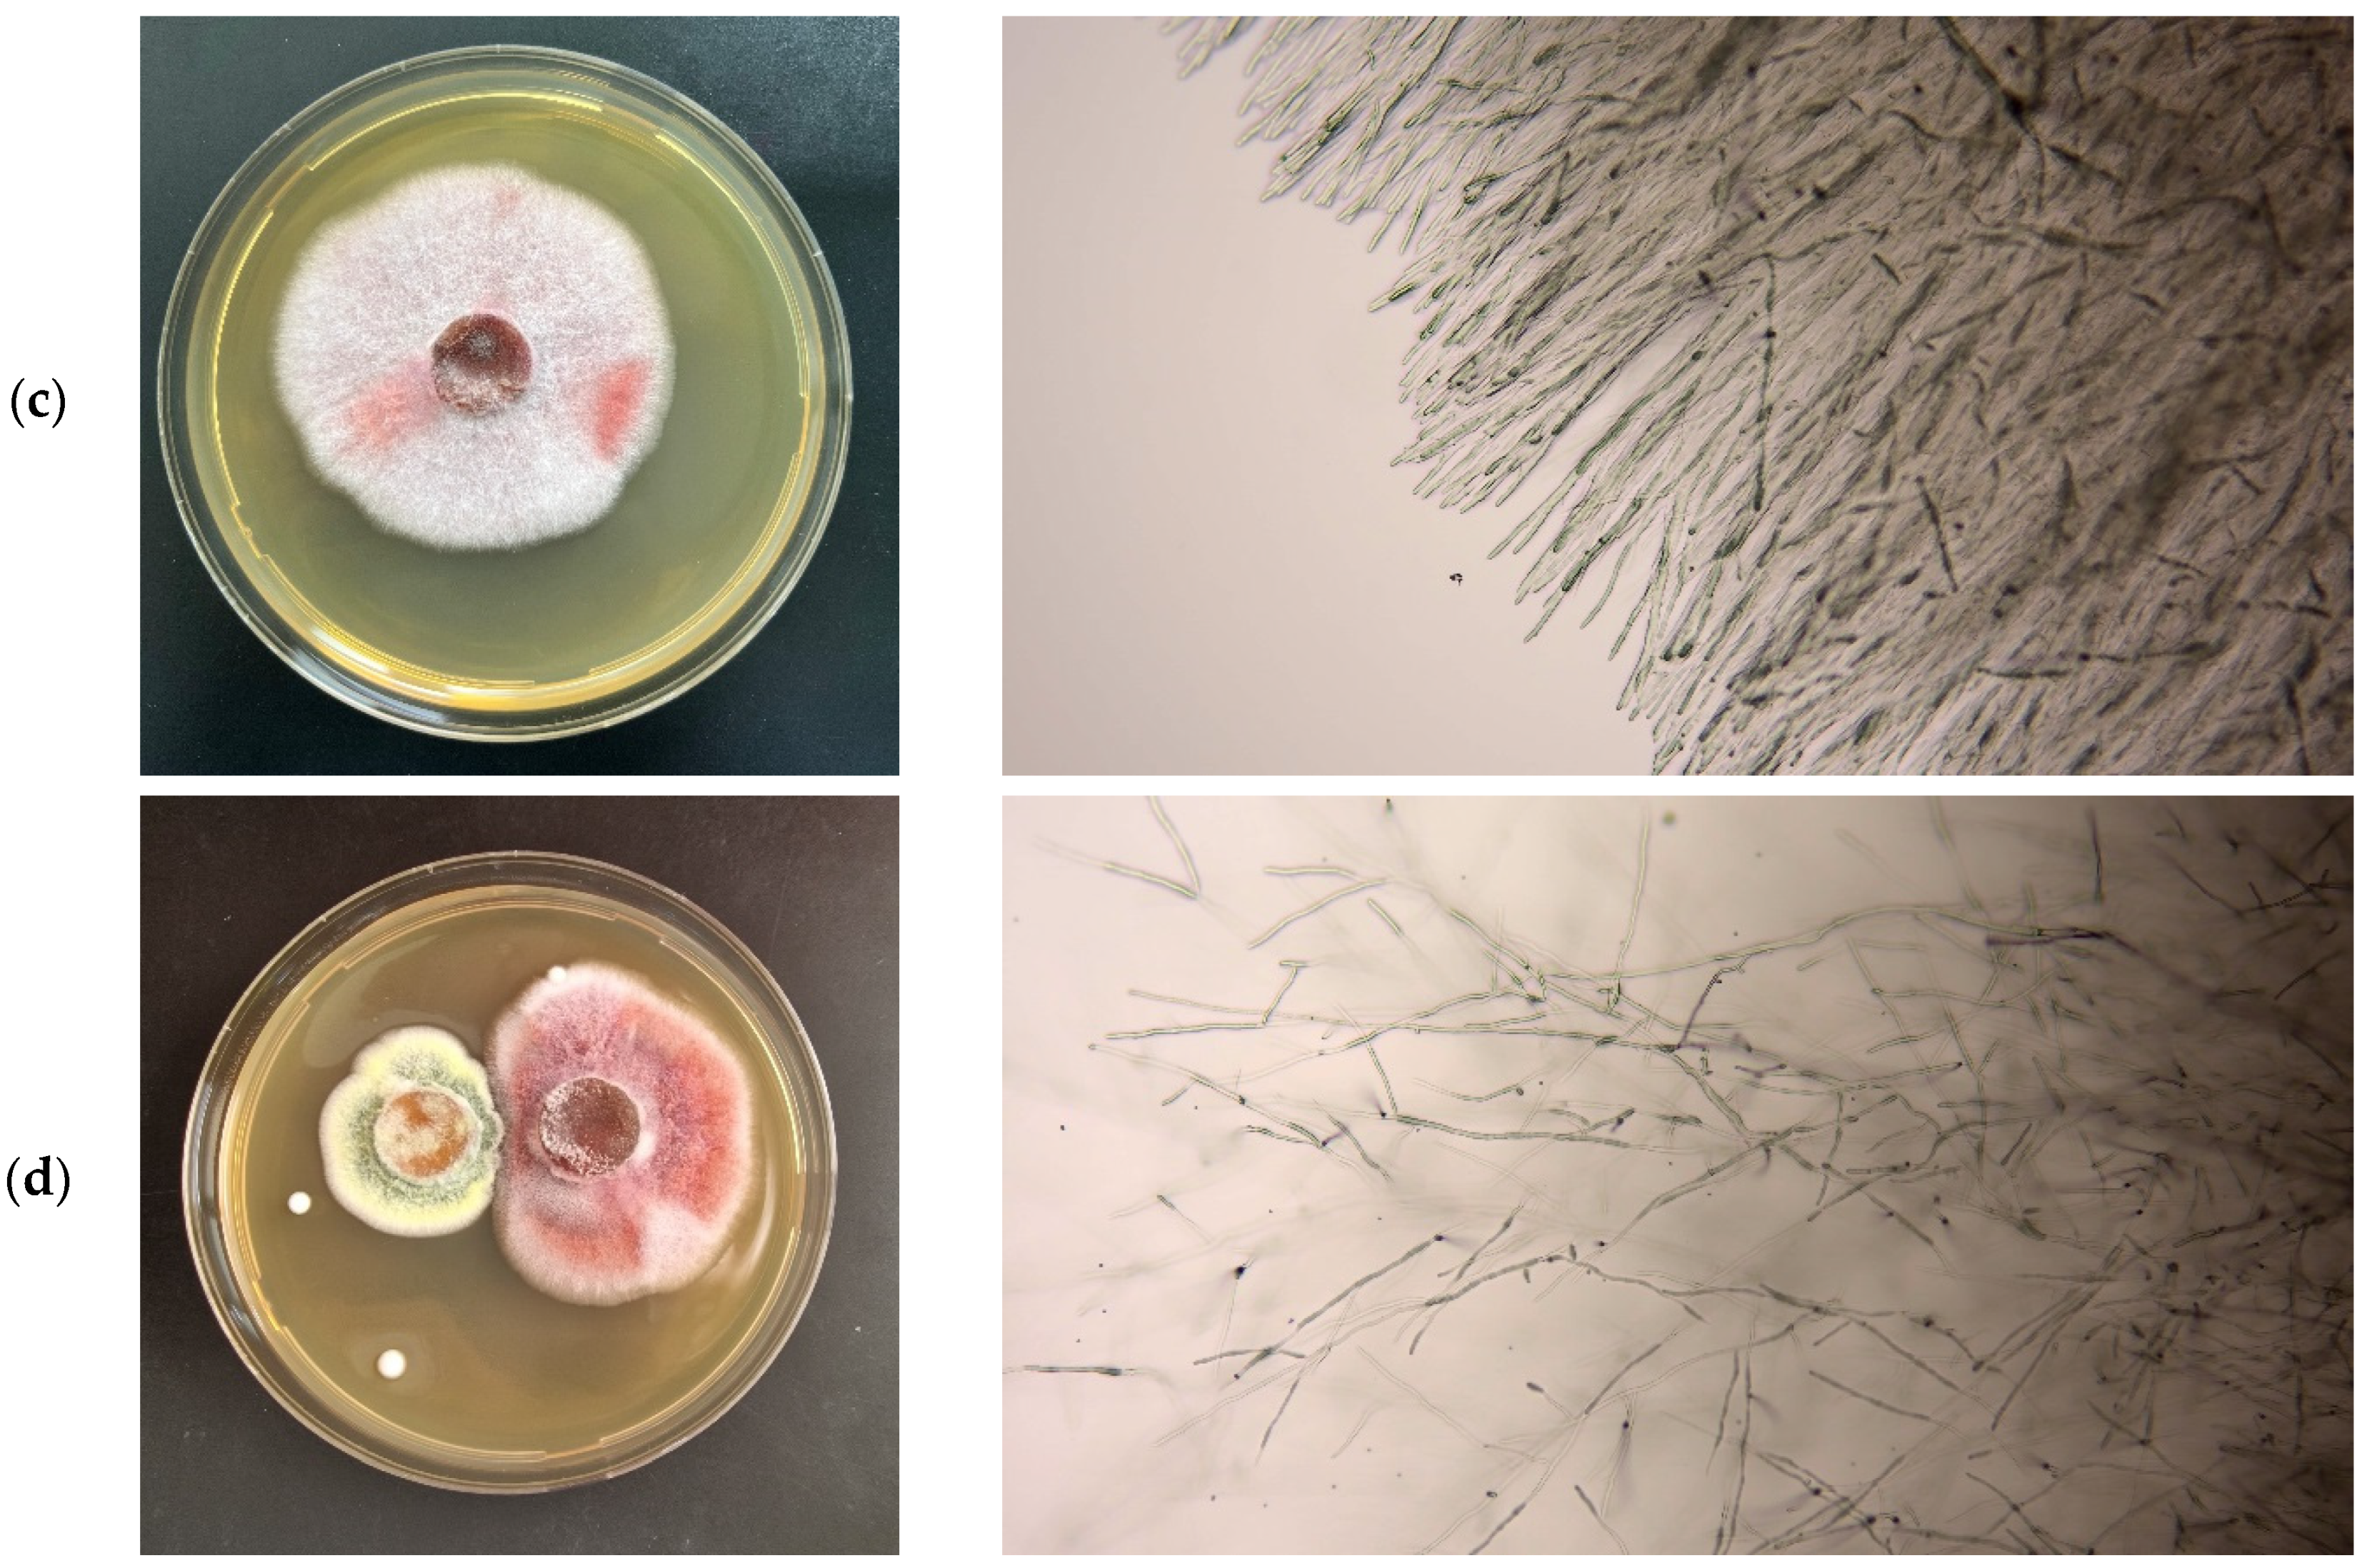
Sustainability 17 00450 g001b

The Antagonistic Activity of Beneficial Fungi and Mechanisms Underlying Their Protective Effects on Plants Against Phytopathogens
Abstract
1. Introduction
2. Materials and Methods
2.1. Materials
2.2. Methods
2.2.1. Study of Antagonistic Activity
2.2.2. Pot Experiments
2.2.3. Determination of the Content of Photosynthetic Pigments
2.2.4. Determination of Proline Content
2.2.5. Determination of ACC Deaminase Activity
2.2.6. Determination of the Activity of Hydrolytic Enzymes
2.2.7. Determination of VOC-Producing Capacity
2.2.8. Extraction of Metabolites from M. robertsii An1 Culture and Evaluation of Antagonistic Activity of Extracts
2.2.9. Chromatographic Analysis of Extracts
2.3. Statistical Analysis
3. Results and Discussion
3.1. Antagonistic Activity of Beneficial Fungi In Vitro
3.2. Antagonistic Activity of Fungal Strains In Vivo
3.3. Study of Mechanisms of Antagonism Against Phytopathogenic Fungi
4. Conclusions
Author Contributions
Funding
Institutional Review Board Statement
Informed Consent Statement
Data Availability Statement
Conflicts of Interest
References
- Giller, K.E.; Delaune, T.; Silva, J.V.; Descheemaeker, K.; van de Ven, G.; Schut, A.G.; van Wijk, M.; Hammond, J.; Hochman, Z.; Taulya, G.; et al. The future of farming: Who will produce our food? Food Secur. 2021, 13, 1073–1099. [Google Scholar] [CrossRef]
- United Nations Sustainable Development Goals. Goal 2: Zero Hunger. Available online: https://www.un.org/sustainabledevelopment/hunger/#:~:text=To%20achieve%20zero%20hunger%20by,global%20nutrition%20and%20food%20security (accessed on 12 December 2024).
- Geng, L.; Li, M.; Zhang, G.; Ye, L. Barley: A potential cereal for producing healthy and functional foods. Food Qual. Saf. 2022, 6, fyac012. [Google Scholar] [CrossRef]
- Stetkiewicz, S.; Burnett, F.J.; Ennos, R.A.; Topp, F.E.C. The impact of fungicide treatment and Integrated Pest Management on barley yields: Analysis of a long term field trials database. Eur. J. Agron. 2019, 105, 111–118. [Google Scholar] [CrossRef]
- Hossain, M.M.; Sultana, F. Application and mechanisms of plant growth promoting fungi (PGPF) for Phytostimulation. In Organic Agriculture; Das, S.K., Ed.; IntechOpen: London, UK, 2020; pp. 1–31. [Google Scholar] [CrossRef]
- Moore, D.; Robson, G.D.; Trinci, A.P.J. Hyphal cell biology and growth on solid substrates. In 21st Century Guidebook to Fungi; Moore, D., Robson, G.D., Trinci, A.P.J., Eds.; Cambridge University Press: Cambridge, UK, 2020; pp. 79–96. [Google Scholar] [CrossRef]
- Frąc, M.; Hannula, S.E.; Bełka, M.; Jędryczka, M. Fungal Biodiversity and Their Role in Soil Health. Front. Microbiol. 2018, 9, 707. [Google Scholar] [CrossRef] [PubMed]
- Chen, J.; Nan, J.; Xu, D.; Mo, L.; Zheng, Y.; Chao, L.; Bao, Y. Response differences between soil fungal and bacterial communities under opencast coal mining disturbance conditions. Catena 2020, 194, e104779. [Google Scholar] [CrossRef]
- de Vries, F.T.; Griffiths, R.I.; Bailey, M.; Craig, H.; Girlanda, M.; Gweon, H.S.; Hallin, S.; Kaisermann, A.; Keith, A.M.; Kretzschmar, M.; et al. Soil bacterial networks are less stable under drought than fungal networks. Nat. Commun. 2018, 9, 3033. [Google Scholar] [CrossRef] [PubMed]
- Baron, N.C.; Rigobelo, E.C. Endophytic fungi: A tool for plant growth promotion and sustainable agriculture. Mycology 2021, 13, 39–55. [Google Scholar] [CrossRef] [PubMed]
- Ghorbanpour, M.; Omidvari, M.; Abbaszadeh-Dahaji, P.; Omidvar, R.; Kariman, K. Mechanisms underlying the protective effects of beneficial fungi against plant diseases. Biol. Control 2018, 117, 47–157. [Google Scholar] [CrossRef]
- Roca-Couso, R.; Flores-Félix, J.D.; Rivas, R. Mechanisms of Action of Microbial Biocontrol Agents against Botrytis cinerea. J Fungi 2021, 7, 1045. [Google Scholar] [CrossRef]
- Karsli, A.; Şahin, Y.S. The role of fungal volatile organic compounds (FVOCs) in biological control. Türk. Biyolojik Mücadele Derg. 2021, 12, 79–92. [Google Scholar] [CrossRef]
- Morath, S.U.; Hung, R.; Bennett, J.W. Fungal volatile organic compounds: A review with emphasis on their biotechnological potential Fungal Biol. Rev. 2012, 26, 73–83. [Google Scholar] [CrossRef]
- Hummadi, E.H.; Cetin, Y.; Demirbek, M.; Kardar, N.M.; Khan, S.; Coates, C.J.; Eastwood, D.C.; Dudley, E.; Maffeis, T.; Loveridge, J.; et al. Antimicrobial Volatiles of the Insect Pathogen Metarhizium brunneum. J Fungi 2022, 8, 326. [Google Scholar] [CrossRef] [PubMed]
- Chandwani, S.; Amaresan, N. Role of ACC deaminase producing bacteria for abiotic stress management and sustainable agriculture production. Environ. Sci. Pollut. Res. Int. 2022, 29, 22843–22859. [Google Scholar] [CrossRef] [PubMed]
- Belimov, A.A.; Zinovkina, N.Y.; Safronova, V.I.; Litvinsky, V.A.; Nosikov, V.V.; Zavalin, A.A.; Tikhonovich, I.A. Rhizobial ACC deaminase contributes to efficient symbiosis with pea (Pisum sativum L.) under single and combined cadmium and water deficit stress. Environ. Exp. Bot. 2019, 167, 103859. [Google Scholar] [CrossRef]
- Erdoğan, O.; Sağlan, Z. Antifungal activity of local isolates of Beauveria bassiana (Balsamo) Vuillemin against Verticillium dahlia Kleb. causing wilt disease of cotton. Egypt. J. Biol. Pest. Control 2023, 33, 52. [Google Scholar] [CrossRef]
- Russo, M.L.; Vianna, M.F.; Scorsetti, A.C.; Ferreri, N.; de Abajo, J.M.; Troncozo, M.I.; Pelizza, S.A. Entomopathogenic Fungi as Dual Control Agents against Two Phytopathogens and the Lepidopteran Pest Rachiplusia nu in Soybean (Glycine max (L.) Merr). J. Fungi 2024, 10, 93. [Google Scholar] [CrossRef]
- Kisaakye, J.; Fourie, H.; Coyne, D.; Cortada, L.; Masinde, S.; Subramanian, S.; Haukeland, S. Evaluation of the Entomopathogenic Potential of Beauveria bassiana, Metarhizium anisopliae and Isaria fumosorosea for Management of Cosmopolites sordidus Germar (Coleoptera: Curculionidae). Agriculture 2021, 11, 1290. [Google Scholar] [CrossRef]
- Carolino, A.T.; Paula, A.R.; Silva, C.P.; Butt, T.M.; I Samuels, R. Monitoring persistence of the entomopathogenic fungus Metarhizium anisopliae under simulated field conditions with the aim of controlling adult Aedes aegypti (Diptera: Culicidae). Parasites Vectors 2014, 7, 198. [Google Scholar] [CrossRef]
- Mnyone, L.L.; Ng’habi, K.R.; Mazigo, H.D.; Katakweba, A.A.; Lyimo, I.N. Entomopathogenic fungi, Metarhizium anisopliae and Beauveria bassiana reduce the survival of Xenopsylla brasiliensis larvae (Siphonaptera: Pulicidae). Parasites Vectors 2012, 5, 204. [Google Scholar] [CrossRef] [PubMed]
- Kirkland, B.H.; Westwood, G.S.; Keyhani, N.O. Pathogenicity of Entomopathogenic Fungi Beauveria bassiana and Metarhizium anisopliae to Ixodidae Tick Species Dermacentor variabilis, Rhipicephalus sanguineus, and Ixodes scapularis. J. Med. Entomol. 2004, 41, 705–711. [Google Scholar] [CrossRef] [PubMed]
- Sui, L.; Lu, Y.; Zhou, L.; Li, N.; Li, Q.; Zhang, Z. Endophytic Beauveria bassiana promotes plant biomass growth and suppresses pathogen damage by directional recruitment. Front. Microbiol. 2023, 14, 1227269. [Google Scholar] [CrossRef]
- Muhorakeye, M.C.; Namikoye, E.S.; Khamis, F.M.; Wanjohi, W.; Akutse, K.S. Biostimulant and antagonistic potential of endophytic fungi against fusarium wilt pathogen of tomato Fusarium oxysporum f. sp. lycopersici. Sci. Rep. 2024, 14, 15365. [Google Scholar] [CrossRef] [PubMed]
- Carrascal-Hernández, D.C.; Flórez-López, E.; Peralta-Ruiz, Y.; Chaves-López, C.; Grande-Tovar, C.D. Eco-Friendly Biocontrol Strategies of Alternaria Phytopathogen Fungus: A Focus on Gene-Editing Techniques. Agriculture 2022, 12, 1722. [Google Scholar] [CrossRef]
- Brazhnikova, Y.V.; Shaposhnikov, A.I.; Sazanova, A.L.; Belimov, A.A.; Mukasheva, T.D.; Ignatova, L.V. Phosphate Mobilization by Culturable Fungi and Their Capacity to Increase Soil P Availability and Promote Barley Growth. Curr. Microbiol. 2022, 79, 240. [Google Scholar] [CrossRef] [PubMed]
- Ignatova, L.; Kistaubayeva, A.; Brazhnikova, Y.; Omirbekova, A.; Mukasheva, T.; Savitskaya, I.; Karpenyuk, T.; Goncharova, A.; Egamberdieva, D.; Sokolov, A. Characterization of cadmium-tolerant endophytic fungi isolated from soybean (Glycine max) and barley (Hordeum vulgare). Heliyon 2021, 7, e08240. [Google Scholar] [CrossRef]
- Brazhnikova, Y.; Ignatova, L.; Omirbekova, A.; Mukasheva, T.; Kistaubayeva, A.; Savitskaya, I.; Egamberdieva, D.; Usmanova, A.; Batlutskaya, I. Effect of plant growth promotion fungi on agricultural crops. Proc. BIO Web Conf. 2021, 40, 01004. [Google Scholar] [CrossRef]
- Khunnamwong, P.; Lertwattanasakul, N.; Jindamorakot, S.; Suwannarach, N.; Matsui, K.; Limtong, S. Evaluation of antagonistic activity and mechanisms of endophytic yeasts against pathogenic fungi causing economic crop diseases. Folia Microbiol. 2020, 65, 573–590. [Google Scholar] [CrossRef] [PubMed]
- Lichtestaller, H.K. Determination of total carotenoids and chlorophylls a and b of leaves extracts in different solvents. Biochem. Soc. Trans. 1983, 11, 591–592. [Google Scholar] [CrossRef]
- Bates, L.S.; Waldren, R.P.; Teare, I.D. Rapid determination of free proline for water-stress studies. Plant Soil 1973, 39, 205–207. [Google Scholar] [CrossRef]
- Honma, M.; Shimomura, T. Metabolism of 1-aminocyclopropane-1-carboxylic acid. Agric. Biol. Chem. 1978, 42, 1825–1831. [Google Scholar] [CrossRef]
- Bradford, M.M. A rapid and sensitive method for the quantitation of microgram quantities of protein utilizing the principle of protein-dye binding. Anal. Biochem. 1976, 72, 248–254. [Google Scholar] [CrossRef]
- Lozano-Tovar, M.D.; Garrido-Jurado, I.; Quesada-Moraga, E.; Raya-Ortega, M.C.; Trapero-Casas, A. Metarhizium brunneum and Beauveria bassiana release secondary metabolites with antagonistic activity against Verticillium dahliae and Phytophthora megasperma olive pathogens. Crop Prot. 2017, 100, 186–195. [Google Scholar] [CrossRef]
- Huang, X.; Han, Y.; Du, J.; Guo, P.; Wang, Y.; Ma, K.; Li, N.; Zhang, Z.; Li, Y.; Pan, J. Inhibitory Effect of Cinnamaldehyde on Main Destructive Microorganisms of Nanhai No. 1 Shipwreck. Appl. Sci. 2021, 11, 5262. [Google Scholar] [CrossRef]
- Yang, F.; Jacobsen, S.; Jørgensen, H.J.L.; Collinge, D.B.; Svensson, B.; Finnie, C. Fusarium graminearum and its interactions with cereal heads: Studies in the proteomics era. Front. Plant Sci. 2013, 4, 37. [Google Scholar] [CrossRef] [PubMed]
- Sharkey, T.D. Emerging research in plant photosynthesis. Emerg. Top Life Sci. 2020, 4, 137–150. [Google Scholar] [CrossRef] [PubMed]
- Liang, X.; Zhang, L.; Natarajan, S.K.; Becker, D.F. Proline mechanisms of stress survival. Antioxid. Redox Signal. 2013, 19, 998–1011. [Google Scholar] [CrossRef] [PubMed]
- Fabro, G.; Kovács, I.; Pavet, V.; Szabados, L.; Alvarez, M.E. Proline accumulation and AtP5CS2 gene activation are induced by plant-pathogen incompatible interactions in Arabidopsis. Mol. Plant-Microbe Interact. 2004, 17, 343–350. [Google Scholar] [CrossRef] [PubMed]
- Belimov, A.A.; Safronova, V.I.; Sergeyeva, T.A.; Egorova, T.N.; Matveyeva, V.A.; Tsyganov, V.E.; Borisov, A.Y.; Tikhonovich, I.A.; Kluge, C.; Preisfeld, A.; et al. Characterization of plant growth-promoting rhizobacteria isolated from polluted soils and containing 1-aminocyclopropane-1-carboxylate deaminase. Can. J. Microbiol. 2001, 47, 642–652. [Google Scholar] [CrossRef] [PubMed]
- Begum, N.; Hu, Z.; Cai, Q.; Lou, L. Influence of PGPB inoculation on HSP70 and HMA3 gene expression in switchgrass under cadmium stress. Plants 2019, 8, 504. [Google Scholar] [CrossRef] [PubMed]
- Mitra, S.; Pramanik, K.; Sarkar, A.; Ghosh, P.K.; Soren, T.; Maiti, T.K. Bioaccumulation of cadmium by Enterobacter sp. and enhancement of rice seedling growth under cadmium stress. Ecotoxicol. Environ. Saf. 2018, 156, 183–196. [Google Scholar] [CrossRef]
- Gupta, S.; Pandey, S. Enhanced salinity tolerance in the common bean (Phaseolus vulgaris) plants using twin ACC deaminase producing rhizobacterial inoculation. Rhizosphere 2020, 16, 100241. [Google Scholar] [CrossRef]
- Robison, M.M.; Shah, S.; Tamot, B.; Pauls, K.P.; Moffatt, B.A.; Glick, B.R. Reduced symptoms of Verticillium wilt in transgenic tomato expressing a bacterial ACC deaminase. Mol. Plant Pathol. 2001, 2, 135–145. [Google Scholar] [CrossRef]
- Golo, P.S.; Gardner, D.R.; Grilley, M.M.; Takemoto, J.Y.; Krasnoff, S.B.; Pires, M.S.; Fernandes, É.K.K.; Bittencourt, V.R.E.P.; Roberts, D.W. Production of destruxins from Metarhizium spp. fungi in artificial medium and in endophytically colonized cowpea plants. PLoS ONE 2014, 9, e104946. [Google Scholar] [CrossRef] [PubMed]
- Sree, K.S.; Padmaja, V. Destruxin from Metarhizium anisopliae induces oxidative stress effecting larval mortality of the polyphagous pest Spodoptera litura. J. Appl. Entomol. 2008, 132, 68–78. [Google Scholar] [CrossRef]
- Yadav, R.N.; Mahtab, R.M.; Zaidi, N.W.; Kumar, R.; Singh, H.B. Secondary Metabolites of Metarhizium spp. and Verticillium spp. and Their Agricultural Applications. In Secondary Metabolites of Plant Growth Promoting Rhizomicroorganisms; Singh, H.B., Keswani, C., Reddy, M.S., Sansinenea, E., García-Estrada, C., Eds.; Springer: Singapore, 2019; pp. 27–58. [Google Scholar] [CrossRef]
- Liu, J.; Leng, L.; Liu, Y.; Gao, H.; Yang, W.; Chen, S.; Liu, A. Identification and quantification of target metabolites combined with transcriptome of two rheum species focused on anthraquinone and flavonoids biosynthesis. Sci. Rep. 2020, 10, 20241. [Google Scholar] [CrossRef] [PubMed]
- Zhao, X.; Wei, J.; Yang, M. Simultaneous Analysis of Iridoid Glycosides and Anthraquinones in Morinda officinalis Using UPLC-QqQ-MS/MS and UPLC-Q/TOF-MSE. Molecules 2018, 23, 1070. [Google Scholar] [CrossRef] [PubMed]
- Ravindran, K.; Chitra, S.; Wilson, A.; Sivaramakrishnan, S. Evaluation of Antifungal Activity of Metarhizium anisopliae Against Plant Phytopathogenic Fungi. In Microbial Diversity and Biotechnology in Food Security; Kharwar, R.N., Upadhyay, R.S., Dubey, N.K., Raghuwanshi, R., Eds.; Springer: New Delhi, India, 2014; pp. 251–255. [Google Scholar] [CrossRef]
- Guigón-López, C.; Holguín-Ibarra, P.D.; Torres-Zapien, J.H.; García- Cruz, I.; Villapando, I.; Salas-Salazar, N.A. Metarhizium anisopliae reduces conidial germination and mycelium growth of the apple gray mold Botrytis cinerea. Biol. Control 2021, 160, 104660. [Google Scholar] [CrossRef]

| Antagonistic Strain | Growth Inhibition, % | Size of Growth Inhibition Zone, mm | ||||
|---|---|---|---|---|---|---|
| Fusarium oxysporum P8 | Fusarium graminearum P12 | Alternaria alternata P15 | Fusarium oxysporum P8 | Fusarium graminearum P12 | Alternaria alternata P12 | |
| Beauveria bassiana T7 | 23.6 ± 1.1 b | 32.3 ± 1.2 b | 37.8 ± 1.6 b | 13 ± 0.4 b | 21 ± 0.8 c | 17 ± 0.7 b |
| Beauveria bassiana T15 | 30.9 ± 1.2 c | 27.7 ± 0.8 c | 22.2 ± 1 a | 17 ± 0.7 c | 18 ± 0.7 b | 10 ± 0.4 a |
| Metarhizium robertsii An1 | 51 ± 1.5 d | 41.5 ± 1.1 d | 48.9 ± 1.8 c | 28 ± 0.9 d | 27 ± 1.1 d | 22 ± 0.8 c |
| Talaromyces pinophilus T14 | 18.2 ± 0.7 a | 20 ± 0.3 a | 35.6 ± 1.5 b | 10± 0.3 a | 13 ± 0.5 a | 16 ± 0.8 b |
| Treatment | Shoot Length, cm | Root Length, cm | Dry Weight of Shoot, g | Dry Weight of Root, g |
|---|---|---|---|---|
| Sterile soil | 17.1 ± 0.5 d | 7.9 ± 0.2 c | 0.045 ± 0.0021 c | 0.019 ± 0.0014 c |
| Soil with Fusarium graminearum P12 | ||||
| Without inoculation | 13.1 ± 0.52 a | 6.3 ± 0.05 a | 0.035 ± 0.0022 a | 0.013 ± 0.0014 a |
| Beauveria bassiana T7 | 15.9 ± 0.4 c | 7.3 ± 0.22 b | 0.041 ± 0.0012 b | 0.018 ± 0.0013 bc |
| Beauveria bassiana T15 | 14.9 ± 0.3 b | 7.1 ± 0.2 b | 0.039 ± 0.001 b | 0.016 ± 0.0012 b |
| Metarhizium robertsii An1 | 16.5 ± 0.5 cd | 7.5 ± 0.3 bc | 0.042 ± 0.002 bc | 0.018 ± 0.0009 bc |
| Talaromyces pinophilus T14 | 15.2 ± 0.2 b | 7.1 ± 0.14 b | 0.039 ± 0.0013 b | 0.016 ± 0.0011 b |
| Treatment | Chl a, mg g−1 | Chl b, mg g−1 | Chl (a + b), mg g−1 | Chl a/b | Proline, µmol g−1 |
|---|---|---|---|---|---|
| Sterile soil | 1.76 ± 0.05 d | 0.64 ± 0.02 b | 2.4 ± 0.08 d | 2.75 ± 0.1 c | 1.28 ± 0.045 a |
| Soil with Fusarium graminearum P12 | |||||
| Without inoculation | 1.33 ± 0.05 a | 0.55 ± 0.01 a | 1.88 ± 0.06 a | 2.42 ± 0.05 a | 2.44 ± 0.08 d |
| Beauveria bassiana T7 | 1.58 ± 0.06 c | 0.61 ± 0.021 b | 2.19 ± 0.05 bc | 2.59 ± 0.1 b | 1.96 ± 0.08 c |
| Beauveria bassiana T15 | 1.55 ± 0.05 bc | 0.62 ± 0.024 b | 2.17 ± 0.1 bc | 2.5 ± 0.05 a | 1.88 ± 0.06 c |
| Metarhizium robertsii An1 | 1.61 ± 0.07 c | 0.6 ± 0.023 b | 2.21 ± 0.08 c | 2.68 ± 0.1 b | 1.65 ± 0.07 b |
| Talaromyces pinophilus T14 | 1.48 ± 0.03 b | 0.56 ± 0.012 a | 2.04 ± 0.04 b | 2.64 ± 0.08 b | 1.72 ± 0.052 b |
| Phytopathogen | Growth Inhibition, % | Size of Growth Inhibition Zone, mm |
|---|---|---|
| Fusarium oxysporum P8 | 12.7 ± 0.5 | 7 ± 1 |
| Fusarium graminearum P12 | 0 | 0 |
| Alternaria alternata P15 | 6.7 ± 0.1 | 3 ± 0.5 |
| Extract Type | Extractive Substances Yield, g L−1 |
|---|---|
| Czapek Dox medium | |
| Filtrate | 0.29 ± 0.01 b |
| Biomass | 0.22 ± 0.016 a |
| Sabouraud medium | |
| Filtrate | 0.48 ± 0.02 b |
| Biomass | 0.34 ± 0.015 a |
| Extract Type | Growth Inhibition, % | ||
|---|---|---|---|
| Fusarium oxysporum P8 | Fusarium graminearum P12 | Alternaria alternata P15 | |
| Czapek Dox medium | |||
| Filtrate | 34.5 ± 1.1 b | 27.7 ± 0.8 b | 33.3 ± 1.4 b |
| Biomass | 20 ± 0.5 a | 15.4 ± 0.4 a | 17.8 ± 0.5 a |
| Sabouraud Medium | |||
| Filtrate | 55.5 ± 1.5 b | 45.4 ± 1.5 b | 54.4 ± 1.6 b |
| Biomass | 35.5 ± 0.7 a | 33 ± 1 a | 36.7 ± 0.8 a |
Disclaimer/Publisher’s Note: The statements, opinions and data contained in all publications are solely those of the individual author(s) and contributor(s) and not of MDPI and/or the editor(s). MDPI and/or the editor(s) disclaim responsibility for any injury to people or property resulting from any ideas, methods, instructions or products referred to in the content. |
© 2025 by the authors. Licensee MDPI, Basel, Switzerland. This article is an open access article distributed under the terms and conditions of the Creative Commons Attribution (CC BY) license (https://creativecommons.org/licenses/by/4.0/).
Share and Cite
Brazhnikova, Y.; Belimov, A.; Ignatova, L.; Mukasheva, T.; Karpenyuk, T.; Goncharova, A. The Antagonistic Activity of Beneficial Fungi and Mechanisms Underlying Their Protective Effects on Plants Against Phytopathogens. Sustainability 2025, 17, 450. https://doi.org/10.3390/su17020450
Brazhnikova Y, Belimov A, Ignatova L, Mukasheva T, Karpenyuk T, Goncharova A. The Antagonistic Activity of Beneficial Fungi and Mechanisms Underlying Their Protective Effects on Plants Against Phytopathogens. Sustainability. 2025; 17(2):450. https://doi.org/10.3390/su17020450
Chicago/Turabian StyleBrazhnikova, Yelena, Andrey Belimov, Lyudmila Ignatova, Togzhan Mukasheva, Tatyana Karpenyuk, and Alla Goncharova. 2025. "The Antagonistic Activity of Beneficial Fungi and Mechanisms Underlying Their Protective Effects on Plants Against Phytopathogens" Sustainability 17, no. 2: 450. https://doi.org/10.3390/su17020450
APA StyleBrazhnikova, Y., Belimov, A., Ignatova, L., Mukasheva, T., Karpenyuk, T., & Goncharova, A. (2025). The Antagonistic Activity of Beneficial Fungi and Mechanisms Underlying Their Protective Effects on Plants Against Phytopathogens. Sustainability, 17(2), 450. https://doi.org/10.3390/su17020450

